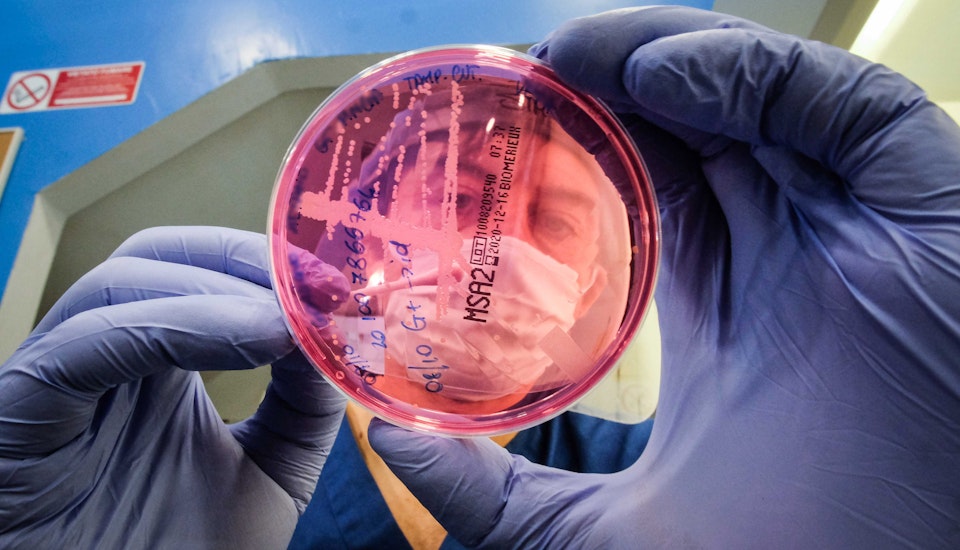

Per offrire un servizio completo ai nostri pet il nostro ospedale ospita due laboratori analisi: uno interno, per gestire le emergenze, ed uno esterno, capace di fornire profili ematici più vasti.
Il nostro laboratorio interno si avvale di macchinari moderni ed avanzati in grado di effettuare analisi in tempo reale (sangue, feci urine, colture micotiche, anticorpali, etc) facendo risparmiare tempo a te ed al tuo pet.
Il laboratorio esterno, sempre ospitato all’interno delle nostre mura, ci permette di abbreviare i tempi di refertazione dal momento che vengono eliminati i tempi di trasporto dei corrieri verso laboratori in altre regioni.
I risultati che otteniamo sono tra i dati fondamentali su cui costruire le diagnosi e, quindi, proporre le terapie più appropriate per i nostri piccoli pazienti.
Per maggiori informazioni sul nostro laboratorio analisi contattaci. Il nostro team è sempre a tua disposizione!